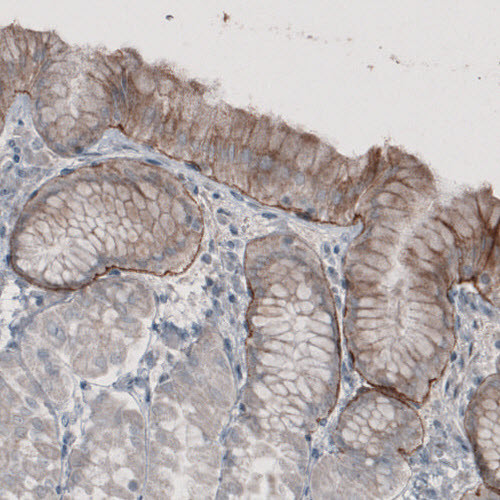
Anti-LAMA3, clone CL3112

Cookie preferences
This website uses cookies, which are necessary for the technical operation of the website and are always set. Other cookies, which increase the comfort when using this website, are used for direct advertising or to facilitate interaction with other websites and social networks, are only set with your consent.
Configuration
Technically required
These cookies are necessary for the basic functions of the shop.
"Allow all cookies" cookie
"Decline all cookies" cookie
CSRF token
Cookie preferences
Currency change
Customer-specific caching
FACT-Finder tracking
Individual prices
Selected shop
Session
Comfort functions
These cookies are used to make the shopping experience even more appealing, for example for the recognition of the visitor.
Note
Show the facebook fanpage in the right blod sidebar
Statistics & Tracking
Affiliate program
Conversion and usertracking via Google Tag Manager
Track device being used
| Item number | Size | Datasheet | Manual | SDS | Delivery time | Quantity | Price |
|---|---|---|---|---|---|---|---|
| ATA-AMAb91123.25 | 25 µl | - |
7 - 10 business days* |
330.00€
|
|||
| ATA-AMAb91123.100 | 100 µl | - |
7 - 10 business days* |
463.00€
|
If you have any questions, please use our Contact Form.
You can also order by e-mail: info@biomol.com
Larger quantity required? Request bulk
You can also order by e-mail: info@biomol.com
Larger quantity required? Request bulk
Protein function: Binding to cells via a high affinity receptor, laminin is thought to mediate... more
Product information "Anti-LAMA3, clone CL3112"
Protein function: Binding to cells via a high affinity receptor, laminin is thought to mediate the attachment, migration and organization of cells into tissues during embryonic development by interacting with other extracellular matrix components. [The UniProt Consortium] Validated by standard strategies. Buffer: 40% glycerol and PBS (pH 7.2). 0.02% sodium azide is added as preservative. Highest antigen sequence identity to mouse: 74% and to rat: 71%. Epitope specificity: EINSLQSDFT.
| Keywords: | Anti-E170, Anti-LAMNA, Anti-LAMA3, Anti-Nicein subunit alpha, Anti-Kalinin subunit alpha, Anti-Laminin subunit alpha-3, Anti-Laminin-7 subunit alpha, Anti-Laminin-5 subunit alpha, Anti-Laminin-6 subunit alpha, Anti-Epiligrin subunit alpha |
| Supplier: | Atlas Antibodies |
| Supplier-Nr: | AMAb91123 |
Properties
| Application: | IHC, WB |
| Antibody Type: | Monoclonal |
| Clone: | CL3112 |
| Conjugate: | No |
| Host: | Mouse |
| Species reactivity: | human |
| Immunogen: | Recombinant Protein Epitope Signature Tag (PrEST) antigen sequence: LLNRIRTWQK THQGENNGLA NSIRDSLNEY EAKLSDLRAR LQEAAAQAKQ ANGLNQENER ALGAIQRQVK EINSLQSDFT KYLTTADSSL LQTNIALQLM EKSQKEYE (ATA-APrEST71201) |
Database Information
| KEGG ID : | K06240 | Matching products |
| UniProt ID : | Q16787 | Matching products |
| Gene ID : | GeneID 3909 | Matching products |
| Protein Atlas Nr. : | ENSG00000053747 |
Handling & Safety
| Storage: | -20°C |
| Shipping: | +20°C (International: +20°C) |
Caution
Our products are for laboratory research use only: Not for administration to humans!
Our products are for laboratory research use only: Not for administration to humans!
Information about the product reference will follow.
more
You will get a certificate here
Viewed